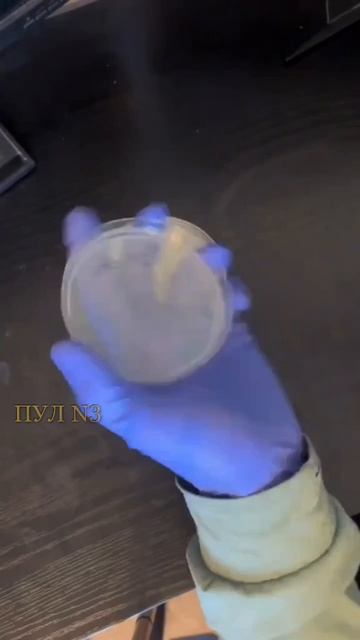
Вредная пицца

МЫШКА КОТОРАЯ ЛЮБИТ ЛАСКУ

Видео
МЫШКА КОТОРАЯ ЛЮБИТ ЛАСКУ
Источник: rutube.ru
⇒ Видео подборки:
Похожее видео
Комментарии ( 0
)
Сначала новые
Сначала старые
Сначала лучшие
Загружено по ссылке
⇒Расскажите об этом видео МЫШКА КОТОРАЯ ЛЮБИТ ЛАСКУ, своим друзьям в социальных сетях.
Ссылка на страницу с видео:
HTML-ссылка на страницу с видео:
Код для вставки плеера:КТО ТАКОЙ САТАН!? НОВЕЙШИЕ ИССЛЕДОВАНИЯ! Полный обзор!!! - стрим пе...
"Опять ересь. Хотя из всех изысканий автора, можно сделать вывод, что сатана есть тот противник Бога в разной ипостаси и разных лицах. Почему автору не подумать что те тексты на которые он опираются могут быть искажены и по своему видению описаны людьми."
(Добавлено: 1776481011.4231)
Десятая Серия Серия „И в Майнкрафт пришёл Новый Год!
"Обожаю твой Сериал! Класс! "
(Добавлено: 1776481011.4231)
КАВЕР ХВОСТА, ЮЛИИ КОГАН Свидание ЖАННА АСТЕР - онлайн
"ОБОЖАЮ"
(Добавлено: 1776481011.4231)
Аренда звука: (495) 969-56-29, аренда света. , - онлайн
"Больше, чем в прошлом году, понравился на этот раз новый светящийся танцпол от прокатной компании "Мистер ВО!"
Свеженьки, чистенький, клетки более крупные.
Дети в восторге!
С уважением, Павел."
(Добавлено: 1776481011.4231)
"дай мне робукс 2500"
(Добавлено: 1776481011.4231)
 Канал:
Канал: